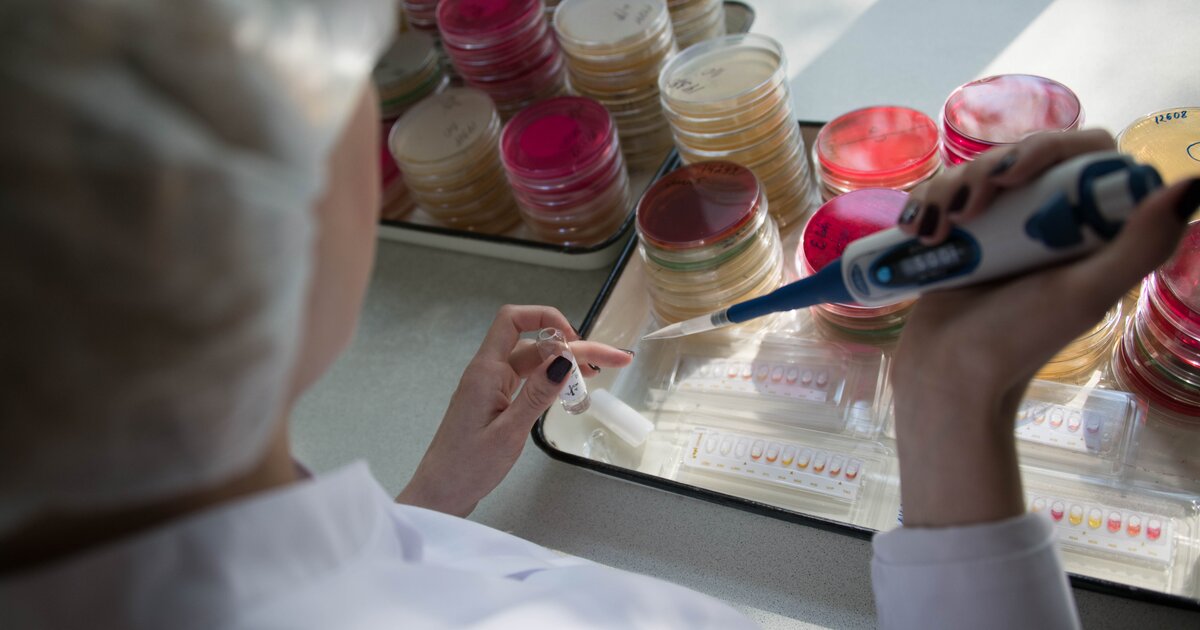

Первые шаги в исследовании: фото и рекомендации













:max_bytes(150000):strip_icc()/scientist-checking-a-solution-in-graduated-cylinder-171274525-59e6903903f4020011307995.jpg)

Раздел: Визуальный дайджест